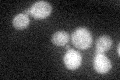
YLR126C
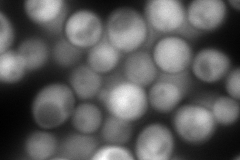
YLR126C
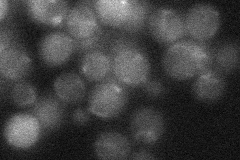
YLR126C

View description
Putative protein of unknown function with similarity to glutamine amidotransferase proteins; has Aft1p-binding motif in the promoter; may be involved in copper and iron homeostasis; YLR126C is not an essential protein
Localization:
Intensity:
Fold change:
Significance:
-
C’ GFP library in SD
cytosol21.12 -
N' NOP1pr-GFP in SD

cytosol134.923 -
N' TEF2pr-mCherry in SD
cytosol324.224 -
N' NATIVEpr-GFP in SD
punctate23.0782 -
N' TEF2pr-VC and Cyto-VN in SD

#N/A0 -
C’ GFP library in SD+DTT

cytosol27.351.29No -
C’ GFP library in SD+H2O2

cytosol24.221.14No -
C’ GFP library in Starvation Media

cytosol19.690.93No -
C’ GFP library on the background of Pup2-DaMP

cytosol -
C’ GFP library on the background of CCT mutant

cytosol20.47250.968835No
